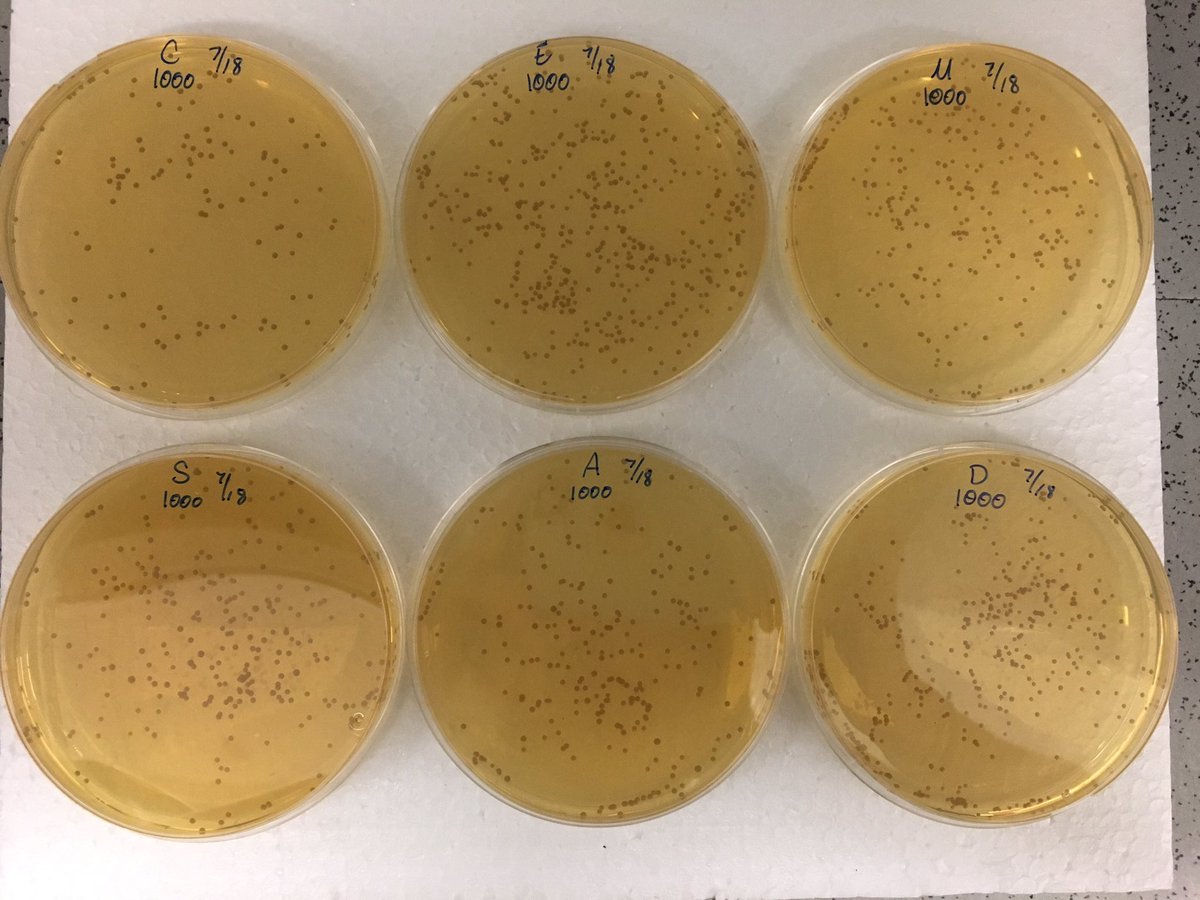
TheErinCarr's tweet image. I feel like 1/2 of my scientific career has just been me counting things #microscopy #hemocytometer #CFUs #myeyesarekillingme

#cfus search results
With the #CFUS #CloudFestUSA hackathon team leads Having lots of great conversations at the @patchstackapp booth today. 🔥 🔥

#Culturelle® ~~~ What Are #CFUs And How Many Do You Need? shareasale.com/r.cfm?b=209631… LIKE▪️SHARE▪️COMMENT
#Culturelle® ~~~ What Are #CFUs And How Many Do You Need? shareasale.com/r.cfm?b=209631… LIKE▪️SHARE▪️COMMENT
🔥 The MiMTSS TA Center team was on fire today curating a #Padlet of favorite Checks for Understanding methods & preparing for their PL Showcase in May! 🎙️ @jdaily_mimtss #CFUs #ProfessionalLearning #ProfessionalDevelopment #RiseAndAlign buff.ly/422k1ug



#CFUs and #Transitions Today #repeat being the best I can be and hope for the best 👍🏾 @DPalomoIbarra
#Culturelle® ~~~ What Are #CFUs And How Many Do You Need? shareasale.com/r.cfm?b=209631… LIKE▪️SHARE▪️COMMENT
#Culturelle® ~~~ What Are #CFUs And How Many Do You Need? shareasale.com/r.cfm?b=209631… LIKE▪️SHARE▪️COMMENT
#Culturelle® ~~~ What Are #CFUs And How Many Do You Need? culturelle.com/learning-cente… LIKE▪️SHARE▪️COMMENT
#BioKult is a capsule formulation containing 14 different bacterial #strains and a dosage of two capsules twice a day is equivalent to 8 billion #CFUs / day. (4/12)
#Culturelle® ~~~ What Are #CFUs And How Many Do You Need? shareasale.com/r.cfm?b=209631… LIKE▪️SHARE▪️COMMENT
#Culturelle® ~~~ What Are #CFUs And How Many Do You Need? shareasale.com/r.cfm?b=209631… LIKE▪️SHARE▪️COMMENT
#Culturelle® ~~~ What Are #CFUs And How Many Do You Need? culturelle.com/learning-cente… LIKE▪️SHARE▪️COMMENT
#Culturelle® ~~~ What Are #CFUs And How Many Do You Need? culturelle.com/learning-cente… LIKE▪️SHARE▪️COMMENT
#Culturelle® ~~~ What Are #CFUs And How Many Do You Need? culturelle.com/learning-cente… LIKE▪️SHARE▪️COMMENT
#Culturelle® ~~~ What Are #CFUs And How Many Do You Need? shareasale.com/r.cfm?b=209631… LIKE▪️SHARE▪️COMMENT
What’s behind the number on your #probiotic label? #CFUs tell an important story about product #quality & consistency. Terry Coyle, Chief #Innovation Officer, explains how understanding CFUs helps #brandowners make smarter formulation & labeling decisions: zurl.co/f2RJ4
UG consultant Meagan Edward working alongside Mrs Hadnot at @EckertES_AISD to create Check for Understanding protocols to use during Eureka Math Concept Development. Why wait until the problem set to find out if students need support? #CFUs #genius 💡



What’s behind the number on your #probiotic label? #CFUs tell an important story about product #quality & consistency. Terry Coyle, Chief #Innovation Officer, explains how understanding CFUs helps #brandowners make smarter formulation & labeling decisions: zurl.co/f2RJ4
With the #CFUS #CloudFestUSA hackathon team leads Having lots of great conversations at the @patchstackapp booth today. 🔥 🔥

New blog: How can you achieve ultra #CleanAir and measure #CFUs in your #OR? bit.ly/1MgLGwy #OperatingRoom

Good luck at the Buffalo Tri Coach Matt and all #CFUS athletes. #SwimBikeRun #FunctionalFitness #DontDrown #USF

Austin is going to represent #CFUS in the Demo derby at #AnokaCountyFair. Come cheer him on #RXThisBitch #DidYouDie

With the #CFUS #CloudFestUSA hackathon team leads Having lots of great conversations at the @patchstackapp booth today. 🔥 🔥


Getting to the affirmative explanations to counter Probiotics Deficiency Criminal Behavior and I’m not losing educating Public benefactor’s #CFUs #ProbioticUpgradeCarriedandApproved Here’s why;



Look at that reflection in our PR Bell. Can't wait for you to get to hear the sound it makes. #ItsYourTime #CFUS

Aimee, Jordan, Terrence, Keith, and Andrew have joined the #CFUS team competing in #Festivus at #BeyondSport on 4/22

#OriginMeals and #xEndurance will be at #CFUS on the morning of Sat the 29th for free tasting. #EatHealthy #Yummy

I feel like 1/2 of my scientific career has just been me counting things #microscopy #hemocytometer #CFUs #myeyesarekillingme
Supporting @WhartonDual’s Math 🧮 Interventionist @ivazquez55 as she createsa @quizizz for her kiddos on Number Bonds. She’s using the audio & the multiple answers features. @HISD_Inst_tech #CFUs #funandegaging


Something went wrong.
Something went wrong.
United States Trends
- 1. #WWENXT N/A
- 2. Sora N/A
- 3. #NCIS N/A
- 4. #SummerHouse N/A
- 5. #Daredevil N/A
- 6. Johnny Gargano N/A
- 7. Zaria N/A
- 8. #LGRW N/A
- 9. Democrat Emily Gregory N/A
- 10. Puka N/A
- 11. Elijah Moore N/A
- 12. Johnny Wrestling N/A
- 13. Hannah Montana N/A
- 14. Mike Santana N/A
- 15. OpenAI N/A
- 16. Tiger N/A
- 17. Robert Plant N/A
- 18. Sol Ruca N/A
- 19. Trump's Mar-a-Lago N/A
- 20. Jordan Clarkson N/A































